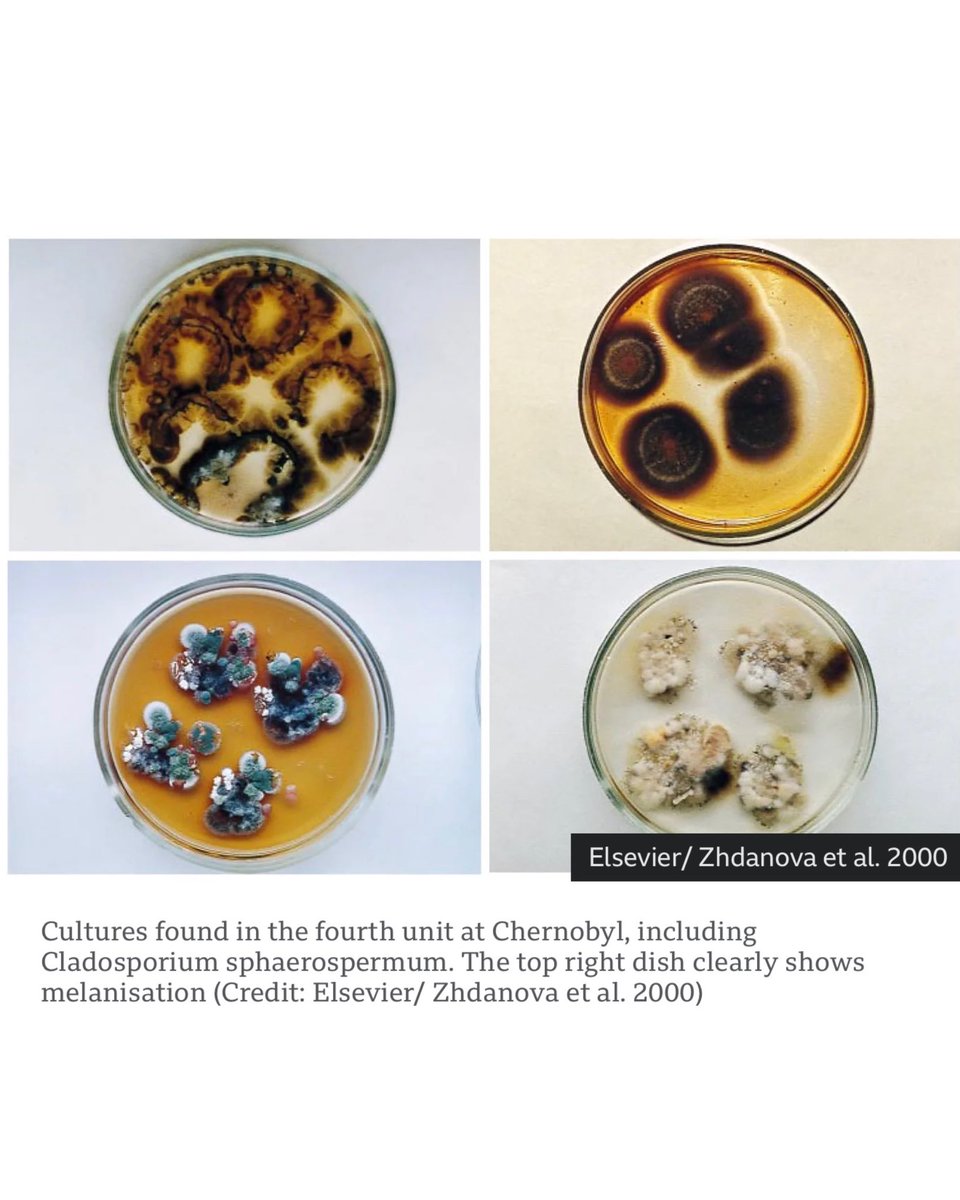
PaulStamets's tweet image. Scientists studying the Chernobyl exclusion zone have identified a melanized fungus that not only survives intense radiation, but may actually metabolize it. A process researchers are calling “radiosynthesis.” 

Findings like this continue to reveal how extraordinary and adaptive…
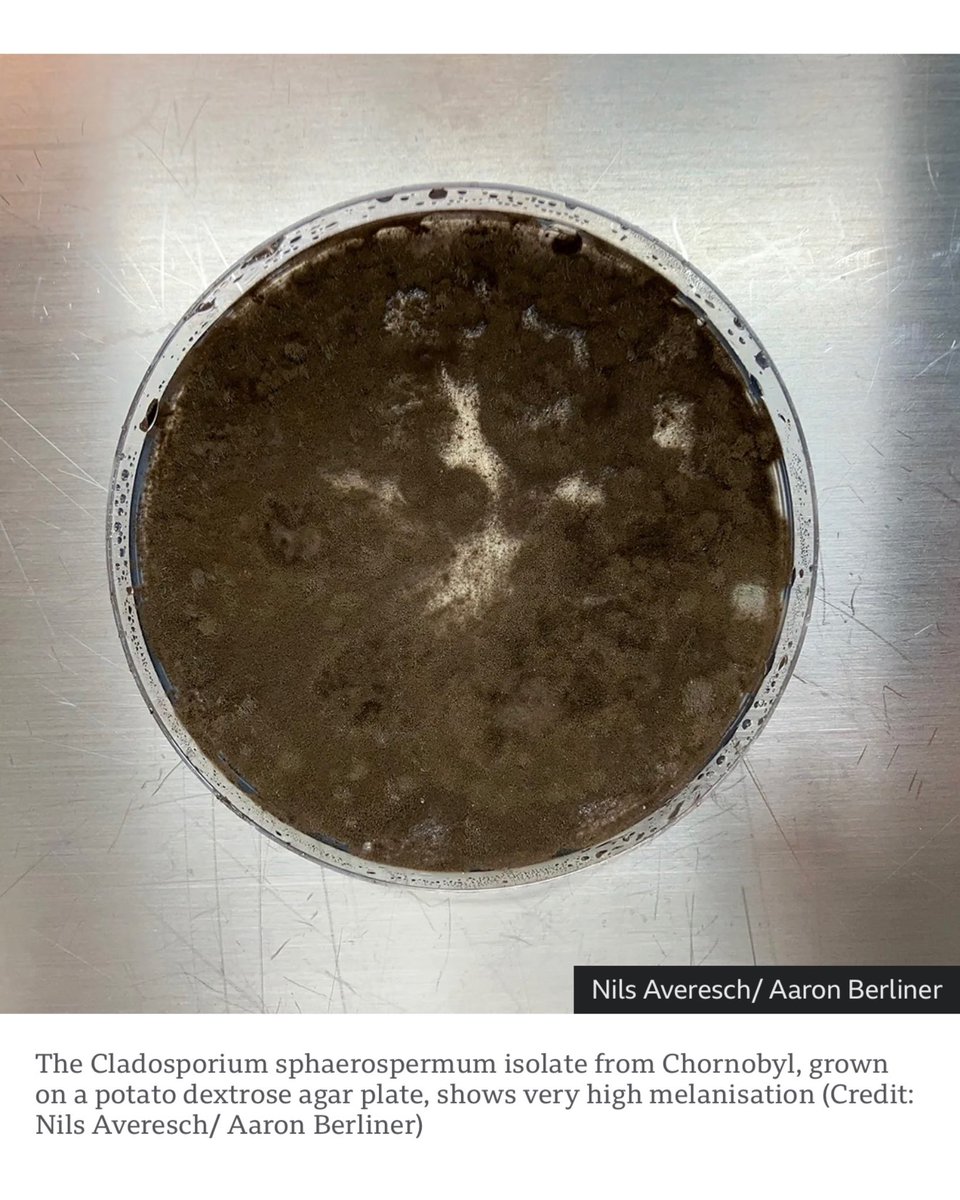
PaulStamets's tweet image. Scientists studying the Chernobyl exclusion zone have identified a melanized fungus that not only survives intense radiation, but may actually metabolize it. A process researchers are calling “radiosynthesis.” 

Findings like this continue to reveal how extraordinary and adaptive…

Another 13 Moon Woman
@enrichedbycode
Another 13 Moon Woman is a “geeky” Bitcoin Artist. Metamodern Indie Animator. Bitcoin ONLY. @A13MW #FreedomTech #Nostr
คุณอาจชื่นชอบ
The African Bitcoin Queen surveys the damage to life and property after Hurricane Melissa! #BitcoinArt #Art #Jamaica #Melissa #NaturalDisaster

At ABC25... where are you at ?? @AfroBitcoinOrg #ABC2025 #ABC25

Our founder just touched down at @AfroBitcoinOrg Africa’s largest Bitcoin conference, and the atmosphere is charged with brilliance 🤗. Mauritius is buzzing with builders, visionaries, and ecosystem shapers. Updates dropping soon, don’t blink 👀 #ABC2025 #Citrusrate

Touch down in Mauritius 🇲🇺🔥 Ready for #ABC2025 , a proudly representing Guinea 🇬🇳🔥🔥🔥 Let’s make it count. @AfroBitcoinOrg 🚀🧡 @GridlessCompute

Live at Africa Bitcoin Conference 2025, Port Louis Mauritius #ABC2025

Our very own @Extheo was recognized as one of the most impactful African Bitcoiners. Thank you @afribitcoiners for this recognition. We are beyond delighted! Mavapay to the world 🚀🚀 #ABC2025

“I have yet to see a Solana Beach or an XRP Valley” Herman of @BitcoinEkasi at #abc2025 talking about why there are circular economies for Bitcoin, but not other cryptos.

I had a great time representing @citrusrate at #BtrustDeveloperDay. Meet my X connects, Bitcoin OGs and citrusrate lovers.




Last night was a vibe!!! Thank you to all who attended the @SatSisterCircle end of year event! Your presence was a true gift! 🔥🔥🔥🔥🔥🔥🔥🔥
Thank you to everyone who joined the @SatoshiSisterCircle end‑of‑year dinner last night in #Mauritius! Your presence, voices, and energy made the night powerful. Here’s to #Bitcoin women rising together, building together, and shining even brighter in the year ahead!!✨🧡

<< he might be one of the most important leaders *ever* >> 🇸🇻👑🗽

"Imagine [@nayibbukele] carries this on. He won't just be the most important leader in El Salvador... he might--by other people doing the same thing in their countries--he might be one of the most important leaders *ever*." - @JeffBooth with @WalkerAmerica on THE Bitcoin Podcast
Ordered & delivered! Thanks for buying from us🧡

9 bitcoiners joined the bitcoin meet up at the bitcoin cafe this morning 🙌
The future of Bitcoin adoption in Africa depends on building and producing our own technology, not merely consuming imported solutions. Powerful keynote by @megasley of @FreeRoutingAf at @AfroBitcoinOrg.

One of my favorite pods we have recorded. Jeff Booth doesn’t hold back on he sees happening in El Salvador
In this episode @JeffBooth walks through his two and a half hour meeting with President @nayibbukele, what they really talked about around Bitcoin, the IMF, self custody, nodes, and circular economies, and why he left the palace more hopeful about El Salvador’s future than when…
Scientists studying the Chernobyl exclusion zone have identified a melanized fungus that not only survives intense radiation, but may actually metabolize it. A process researchers are calling “radiosynthesis.” Findings like this continue to reveal how extraordinary and adaptive…

Freedom isn’t just financial, it’s movement, identity, and unity. Farida challenges us to shed colonial mindsets, rethink borders, and build spaces for those who believe in true freedom. Some powerful quotes from her welcome address! #ABC2025 #Mauritius #ABC25 #Bitcoin




This is value. 👇🏾👇🏾👇🏾
Why you should buy your Adopting Bitcoin Cape Town ticket? Below are some of the benefits: 1) Tote bag & sticker pack ✅ 2) Pecha Kucha presentation invitation✅ 3) Bitcoin Loxion Guided Tour ✅ 4) Complimentary access to the African Bitcoin Circular Economy Summit 👇 5) TBA 👀…



United States เทรนด์
- 1. #AEWDynamite 14K posts
- 2. Giannis 72K posts
- 3. #Survivor49 1,981 posts
- 4. #iubb 1,044 posts
- 5. Jamal Murray 2,200 posts
- 6. #TheChallenge41 1,137 posts
- 7. Kevin Knight 1,482 posts
- 8. #SistasOnBET 1,294 posts
- 9. Dark Order 1,368 posts
- 10. Achilles 4,882 posts
- 11. Spotify 1.94M posts
- 12. Bucks 45.2K posts
- 13. Steve Cropper 2,861 posts
- 14. Spurs 29.1K posts
- 15. Yeremi N/A
- 16. Lonzo 1,017 posts
- 17. Mikel 34.1K posts
- 18. Luke Kornet 1,126 posts
- 19. Rizo N/A
- 20. DeVries N/A
Something went wrong.
Something went wrong.


























































































































































